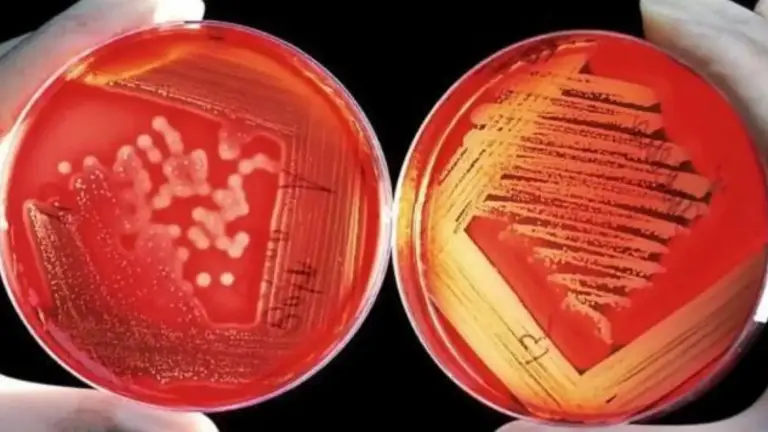

De acuerdo con el Centro Europeo para el Control y la Prevención de Enfermedades (eCDC, por sus siglas en inglés), se está propagando en el continente una bacteria denomina Klebsiella pneumoniae hipervirulenta (hvKp ST23) resistente a carbapenemas, antibióticos de último recurso.
Esto también podría interesarte: ÚLTIMA HORA | Maduro ofrece balance sobre muertos y heridos en mina "Bulla Loca"
"Klebsiella pneumoniae es una bacteria patógena humana que está en el punto de mira por ser una de las que actualmente tiene cepas resistentes a muchos de los antibióticos de uso humano conocidos”, explicó Raúl Rivas, catedrático de Microbiología de la Universidad de Salamanca, a El Español.
Esto también podría interesarte: Petroleros de Texas quieren invertir en Venezuela
“Es una de las famosas bacterias multirresistentes y está como objetivo de prioridad crítica de la OMS para seguirla”, agregó.
Esto también podría interesarte: Casa Blanca evalúa restringir la posibilidad de solicitar asilo en la frontera
Expertos en la materia avisan que puede ser el causante de la siguiente crisis de salud mundial
Visita nuestra sección Internacionales
Para mantenerte informado sigue nuestro canal en Telegram https://t.me/Diario2001Online
Sigue el canal de 2001online en WhatsApp: https://whatsapp.com/channel/0029Va9CHS8EwEk0SygEv72q